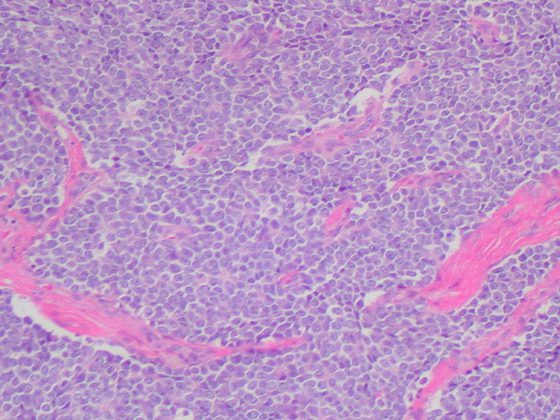
ewing-sarkom

Chirurgische Resektion stellt den Hauptpfeiler der Therapie von Knochensarkomen des Beckens dar. Die Behandlung ist komplex und sollte individualisiert erfolgen. Durch Austausch von Daten und Expertenwissen kann die Erkrankung besser verstanden werden. Ein Ansatz hierfür bildet das SwissSarcomaNetwork.